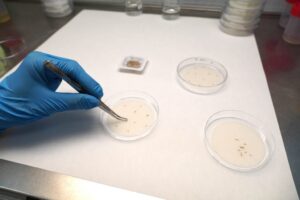

Thales recibe certificación de seguridad de eSIM por parte de GSMA
9 de julio de 2025

Apple impugna ante la UE una multa de 500 millones de euros
8 de julio de 2025

Multa de €530 millones a TikTok por violaciones de privacidad en la UE
5 de mayo de 2025

SES negocia con la UE para complementar servicios de Starlink
1 de mayo de 2025

ENISA abre solicitudes para nuevos miembros ad personam del Grupo Asesor
27 de febrero de 2025